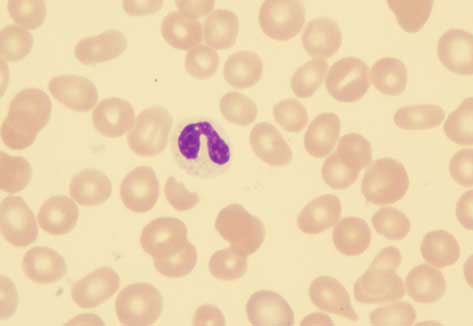

We handle cases across the United States. Allen Stewart is licensed to practice law in Texas, California, New York, Pennsylvania, Missouri, North Carolina, Ohio and Arizona.
Myelodyplastic Syndrome
Benzene Exposure Attorney
If you have been diagnosed with myelodysplastic syndrome and you suspect that it may be related to benzene exposure, please contact us for a free consultation. You should know your legal rights.
Recent medical and scientific studies demonstrate that benzene exposure causes myelodysplastic syndrome, also known as MDS. Our law firm has helped benzene exposed people across the United States recover monetary settlements and jury verdicts for their injuries. Below you will find a true story about one of our clients.
An Occupational Carpet and Upholstery Cleaner Contracts MDS
He started his own carpet and upholstery cleaning business thirty years ago. Day in and day out, he used solvents and cleaners that contained the cancer causing chemical called benzene. The solvents and cleaner containers didn’t say the products contained benzene, so he didn’t know that every day he worked with these products he breathed in excessive levels of benzene.
One day, he began feeling overly tired and visited a doctor. After some blood tests, he was sent to cancer doctors who diagnosed him with myelodysplastic syndromes, also known as MDS. Over time his MDS became acute myeloid leukemia, also known as AML. His disease progressed in a way that doctors recommended a stem cell transplant. Unfortunately, his benzene related MDS/AML took his life.
Before he died, the occupational carpet and upholstery cleaner contacted our law firm and decided to file a lawsuit against the solvent and cleaner manufacturers for their negligence in producing products without adequately informing users like him of the dangers posed by the ingredients. Before trial, our legal team negotiated a confidential settlement on his family’s behalf.
View the list of occupations that may expose you to benzene.
We have an experienced team of lawyers to help you. Our principal office are located in Dallas, Texas, but we have attorneys licensed to practice law in Arizona, California, Pennsylvania, New York, Missouri, and Texas. We also have represented clients in many other states through co-counsel agreements with attorneys licensed in those states.
If you have been diagnosed with myelodysplastic syndrome and you suspect that it may be related to benzene exposure, please contact us for a free consultation. You should know your legal rights.
